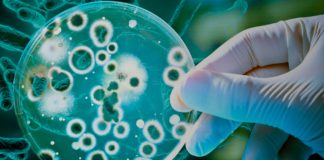
La guerra de los mundos o nuestra alianza con las bacterias Las bacterias - Cantineoqueteveonews

Etiqueta: Revista Nature
Sexualidad
Comunidad LGBTIQ
Coronavirus
Vídeos
Las redes 5G llegan con las nuevas llamadas cara a cara
Es posible que en los próximos meses gracias a la novedosa tecnología 5G se inicien las impresionantes llamadas cara a cara...
¡Ya es un hecho! Presentado trailer de Novigrad
Para los fanáticos de Gwent, el juego de cartas que salió de The Witcher; tenemos grandes noticias: la próxima expansión, Novigrad,...